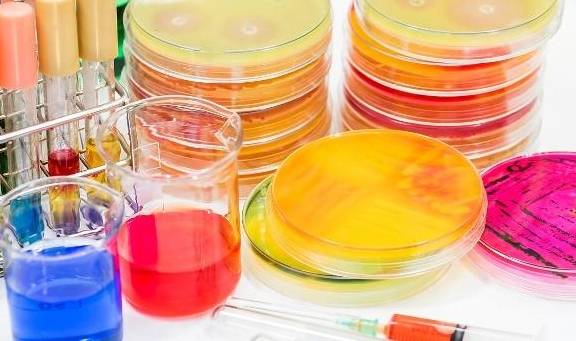
肾脏|尿有泡沫是怎么回事?常吃这6种食物来防止泡沫尿

肾脏|尿有泡沫是怎么回事?常吃这6种食物来防止泡沫尿
文章图片
我们人体的尿液 , 除了含有大部分的水分外 , 还含有极少量的泡沫 。 尿液中泡沫的形成 , 是液体表面张力高所致 。 表现张力越高 , 形成的泡沫越多 。
假如尿液中的成分发生变化 , 如蛋白质、黏液量和有机物质增多 , 也可产生泡沫 , 这是蛋白质表面张力低所致 。 这是如果有其他肾病症状 , 就需要请肾脏科专家详细检查 。
1 , 泡沫尿液有可能是蛋白尿的最早期表现 , 蛋白尿是指尿中胆汁盐或者白蛋白增多 。 蛋白尿是肾脏受损和心脏病的标志 , 特别是对于患有高血压或糖尿病的人 。

文章图片
2 , 泡沫尿往往是肾脏综合征的第一个表现 。 肾脏综合征是一种很严重的肾病 , 由于病毒感染、糖尿病或者狼疮而致使肾脏过滤功能受损 , 这样大量蛋白质就进入到尿中 , 形成蛋白尿 。
3 , 尿中的泡沫也可能是膀胱与阴道或者直肠之间有瘘管的信号 。 很多疾病 , 包括克罗恩式病以及肿瘤都可能导致瘘管形成 。
那么因肾病引发的泡沫尿通过食疗能改善吗?一下6种食物对补肾都有很好的作用 。

文章图片
1 , 芝麻 。 肾虚之人腰酸腿软 , 头昏耳鸣 , 发苦发落及早年白发 , 大便燥结的人最适合吃 。
2 , 粟米 。 肾病之热适合吃 , 可熬粥服用 , 益丹田 , 补虚损 。
3 , 牛骨髓 。 对肾虚羸瘦、精血亏损之人最合适 。
4 , 狗肉 。 肾阳不足、要膝软弱或冷痛的人最适合服用 。
5 , 羊骨 。 能补肾强筋骨 , 益肾明日 。
【肾脏|尿有泡沫是怎么回事?常吃这6种食物来防止泡沫尿】6 , 猪肾 。 肾虚所导致的腰酸背痛、遗精、盗汗和老人肾虚耳鸣耳聋 , 可多食用 。
- 零下度|冬季天气寒冷身体变虚弱了,多吃家常菜,补血养肝有利健康
- 疫苗|【992 | 速看】传播能力有所增强!有关奥密克戎变异株,最新解答来了!
- 患上糖尿病|隔代也会遗传糖尿病?关于糖尿病的5个冷知识,你了解多少?
- 治疗|糖尿病服药后,出现的低血糖比较严重怎么办?
- 进行|尿毒症多半是“吃”出来的?3种食物尽量少碰,肾或许“感谢”你
- 过量食肉带来的危险 你知道么
- 营养专家告诉您 剩菜打包有方法
- 肠镜|肠镜选无痛好还是普通好?二者有何区别?不妨听听医生的分析!
- 治疗|治疗运动神经元的方法有哪些呢?
- 饮食|正糖名家提醒,糖尿病这些误区不可不知!
